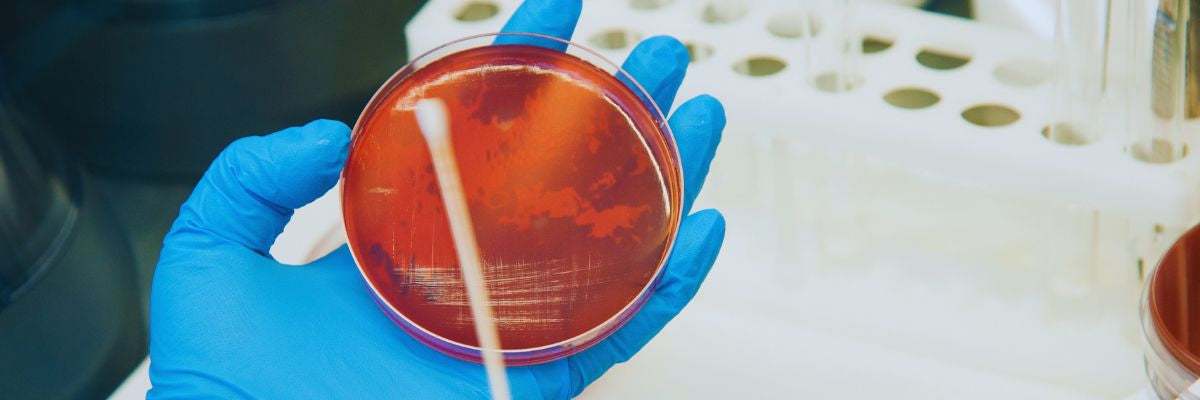

FREE SHIPPING ON
ORDERS $500+

Figure 1 - B. bruxellenis from DME Agar at 800x Light Magnification (Bootleg Biology, 2019)
A genus of yeast which was first documented to contribute to stock ales of the 19th century, it is responsible for part of the terroir of the tertiary fermentation of Lambic and Flanders ales. The genus consists of five species with two found in the brewery, B. bruxellensis and B. anomalus. Considered a contaminant as it can contribute undesirable flavours and aromas; it has been viewed as a new type of yeast for experimentation by craft brewers (Yakobson, 2012). It can be used to increase profile complexity. Brettanomyces is an asexual budding anamorph and can ferment in aerobic and anaerobic conditions. Brettanomyces follows similar pathways to Saccharomyces; however, Brettanomyces can produce more phenolic compounds such as 4-ethylguaciacol and 4-ethylphenol and more esters such as ethyl caproate, ethyl caprylate, and ethyl decanoate (Tyrawa, 2019).

Figure 2 - Comparison of ester & phenol production at 15°C & 22.5°C between Saccharomyces (US-05) and several Brettanomyces strains (Preiss, 2019).

Figure 3 - L. delbrueckii Grown on MRS Agar at 2000x Liquid Magnification (Bootleg Biology, 2019)
Lactobacillus is a genus of bacteria of a group known as lactic acid bacteria (LAB). Other LAB used in food fermentation include Lactococcus, Streptococcus, Pediococcus, and Leuconostoc. The metabolic pathways for LAB are glycolysis, lipolysis, and proteolysis, which is the formation of lactic acid from sugar, fat, and protein, respectively. Other fermentation products include diacetyl, acetoin, acetaldehyde or acetic acid (Bintsis, 2018). Species of lactobacillus found in a brewery setting include L. brevis, L. lindneri, and L. delbrueckii. Lactobacillus are rod-shaped, facultatively anaerobic, and gram-positive. Lactobacillus grow best near 30°C with a pH between 4.0-5.0 (White, 2012). Considered a contaminant for brewing applications, there are several styles of beer that require Lactobacillus. Examples include Berliner Weiss, Flanders Red Ale, Oud Bruin, Lambic, Gueuze; it can contribute to Witbier and Saison; and used in styles of Gose and Litchtenhainer (Strong and England, 2015). Barley malt has populations of Lactobacillus on the husks. Some brewers will use a small amount of malt to inoculate unhoped wort for souring, this can aid for mash or kettle acidification (White, 2012).

Figure 4 - Pediococcus Grown on MRS Agar at 2000x Liquid Magnification (Bootleg Biology, 2019)
Pediococcus is a genus of coccocoidal or ovid shaped LAB. They are gram-positive, produce lactic acid from glycolysis, and grow best at a pH between 4.0-5.0 (Priest, 2012). They are non-motile and non-spore forming; typically, they do not produce carbon dioxide, ethanol, or acetic acid (Wade et al., 2018). Considered a contaminant apart from certain sour beers, as they contribute diacetyl, turbidity, and acid formation; as well as they form extracellular polysaccharides which appear as a “ropey” viscous substance (Priest, 2012). Due to the division mechanism of Pediococcus cells, they often appear to be in small clusters and are the only LAB in beer to do this, which allows identification with a microscope (Wade et al., 2018).
Saccharomyces is a genus of unicellular fungi known as "yeast". The most common species used can be classified as S. cerevisiae, S. pastorianus, or S. cerevisiae diastaticus. Saccharomyces perform a fermentation of short polysaccharides to produce alcohol, carbon dioxide, and flavours and aromas that are associated with beer. Strains from this genus are anamorphs, where aerobic conditions encourage cell growth, and anaerobic conditions encourage alcohol production (Van Zandycke, 2012).

Figure 5 - S. cerevisiae from DME Agar at 800x Light Magnification (Bootleg Biology, 2019)
S. cerevisiae is the most common species. Critical in the fermentation of beer, wine, spirits wash, sake and in the production of bread. S. cerevisiae is categorized as a "top-fermenting" yeast as it produces a thick layer of krausen during fermentation and are used primarily for ales. S. cerevisiae carries out fermentation at temperatures of 18°C-24°C. They are known for ester production that leads to a more complex profile. Over 200 different strains of S. cerevisiae are commercially available (Dunn, 2012).

Figure 6 - S. pastorianus from DME Agar at 800x Light Magnification (Bootleg Biology, 2019)
S. pastorianus, or lager yeast, is a hybridization of S. cerevisiae and S. eubayanus (Libkind et al., 2011). It is physiologically different from S. cerevisiae; ferments at cooler temperatures and can process melibiose. S. pastorianus typically has a higher degree of attenuation with lower levels of ester formation, establishing the profile of lagers. S. pastorianus were selected unintentionally from brewing practises resulting from the Reinheitsgebot which restricted brewing during the summer (Sherlock, 2012).

Figure 7 - S. diastaticus from DME Agar at 800x Light Magnification (Bootleg Biology, 2019)
S. diastaticus can attenuate higher than S. cerevisiae by consuming starch and dextrins. Complex polysaccharides escape digestion by S. cerevisiae, S. diastaticus produces glucoamylase. Glucoamylase cleaves the 1-4 linkages in amylose while leaving the 1-6 linkages in amylopectin (Andrews and Gilliland, 1952). Dextrins contribute to body and mouthfeel of the final beer, not consumable by S. cerevisiae, but are fermented when S. diastaticus is present. S. diastaticus cannot be identified from S. cerevisiae using plating methods; a polymerase chain reaction must be used to identify the glucoamylase genetic marker: STA1. S. diastaticus is an issue in brewing as STA1 is common with Saison-style yeasts. Sources include: an increase in craft-scale brewing, market demands increasing the variety of yeast strains, and lacking in equipment such as pasteurization units, kieselguhr-based filtration, and automated clean-in-place. Contamination of S. diastaticus can result in higher alcohol, phenolic flavours, over-carbonation, and final package failure. Cellar management that avoids cross-contamination of yeast and brewing wort with reduced levels of dextrins can be used to lower the mentioned risks (Ferguson, 2018).
Kveik is a Norwegian dialect word for "yeast', and in English, it refers to a mixed culture of S. cerevisiae used for hundreds of years in traditional farmhouse brewing. As a verb in Norwegian, it means to "begin life" (Geithung, 2019). Common traits among Kveik cultures are high-flocculation, low phenols, quick fermentations while being high temperature tolerant. They are a genetically distinct group of S. cerevisiae, and have direct applications to brewing, allowing for faster fermentations and lower cooling requirements. Kveik cultures also have a high degree of alcohol tolerance. Kveik cultures produce more of ethyl caproate, ethyl caprylate, ethyl decanoate, and phenethyl acetate compared to monoculture S. cerevisiae (Preiss et al., 2018).

There are several areas of minimum sampling to identify beer spoilage organisms. The main goal is to evaluate cleaning procedures and update methods to remove contaminants.
|
Test |
Sample Area |
Frequency |
|
Forced Wort |
After wort chilling Prior to adding yeast |
With each batch of wort |
|
Clean-In-Place Swab |
Interior of Equipment |
After Cleaning Prior Use |
|
HLP |
Holding Vessel or Package |
After Beer Transfer |
Table 1 - Proposed Sampling Procedure
A forced wort test is a determination of the cleanliness of the wort chiller. If the wort chiller has been appropriately maintained and cleaned to the proper degree, there should be no growth in a sample that has no inoculate.
|
Time (Days) |
Result |
|
1 |
Extremely dirty pathway. Dump beer. |
|
2-3 |
Major Contamination. May spoil beer. Do not reuse yeast. |
|
3-6 |
Minor Contamination. May not affect beer. |
|
7+ |
Very Clean. |
Table 2 - FWT Haze Results (Jones, 2018)
A cleaning verification method is a swab test; it can identify growth not removed by clean-in-place or clean-out-place procedures. Sampling areas that encounter beer will ensure a stable product. Several example areas are fermenter connections, hard-piping ports, the wort chiller, or any filters.
HLP media detects Lactobacillus and Pediococcus and designed to simplify procedures. It is a low-cost preparation that contains the yeast inhibitor Actidione and an oxygen scavenger. It is semi-solid and semi-aerobic.
MaterialsWhen brewing, the equipment is typically cleaned and sanitized. When preparing a fresh sample for yeast growth, a sterile environment is needed to ensure that unwanted micro-organisms do not propagate alongside. Sterile materials can be achieved with a wet environment for 15m at 121°C or in a dry environment for 2h at 160°C (White and Zainasheff, 2010).

Figure 9- Flow Diagram of a Proposed Laboratory Propagation of Brewing Yeast (Bolton & Quain, 2008)
Andrews, B. and Gilliland, R. 1952. Super-Attenuation of Beer: A Study of Three Organisms Capable of Causing Abnormal Attenuations. Journal of the Institute of Brewing, 58(3), pp.189-196.
Boulton, C. and Quain, D., 2013. Brewing Yeast and Fermentation. Hoboken: Wiley.
Bintsis, T., 2018. Lactic acid bacteria as starter cultures: An update in their metabolism and genetics. AIMS Microbiology, 4(4), pp.665-684.
Bootleg Biology. 2019. DIYeast: Microbe Portrait Gallery. [online] Available at: https://bootlegbiology.com/diy/microbe-portrait-gallery/ [Accessed 16 Nov. 2019].
Dunn, B., 2012. Ale Yeast. In: The Oxford Companion to Beer, 1st ed. New York: Oxford University Press, pp.33.
Ferguson, N., 2018. Understanding (Over)attenuation, Carbonation, and Bursting: AKA Understanding Diastaticus.
Geithung, I., 2019. In Norway, Kveik Means More Than Just Yeast. [video] Available at: https://www.youtube.com/watch?v=MCC3tBS2j_Q [Accessed 16 Nov. 2019].
Jones, N. 2018. Yeast Management on a Budget.
Libkind, D., Hittinger, C., Valerio, E., Goncalves, C., Dover, J., Johnston, M., Goncalves, P. and Sampaio, J., 2011. Microbe domestication and the identification of the wild genetic stock of lager-brewing yeast. Proceedings of the National Academy of Sciences, 108(35), pp.14539-14544.
Manufacturing.net. 2014. How to Swab For Bacterial Contamination in Your Brewery. [online] Available at: https://www.manufacturing.net/operations/blog/13190255/how-to-swab-for-bacterial-contamination-in-your-brewery [Accessed 16 Nov. 2019].
Pellettieri, M. (2015). Quality Management: Essential Planning for Breweries. 1st ed. Boulder, Colorado: Brewers Publications, p.81.
Palmer, J. 2017. How to Brew. 4th ed. Boulder, Colorado: Brewers Publications.
Preiss, R., Tyrawa, C., Krogerus, K., Garshol, L. and van der Merwe, G., 2018. Traditional Norwegian Kveik Are a Genetically Distinct Group of Domesticated Saccharomyces cerevisiae Brewing Yeasts. Frontiers in Microbiology, 9.
Preiss, R., 2019. Don't Forget The Brett. [online] Escarpment Laboratories. Available at: https://www.escarpmentlabs.com/single-post/2019/08/14/Dont-forget-the-Brett [Accessed 16 Nov. 2019].
Priest, F., 2012. Pediococcus. In: The Oxford Companion to Beer, 1st ed. New York: Oxford University Press, pp.644.
Sherlock, G., 2012. Lager Yeast. In: The Oxford Companion to Beer, 1st ed. New York: Oxford University Press, pp.535.
Strong, G. and England, K. (2015). 2015 Style Guidelines. [online] Beer Judge Certification Program. Available at: https://bjcp.org/docs/2015_Guidelines_Beer.pdf [Accessed 16 Nov. 2019].
Tyrawa, C. et al., 2019. The temperature dependent functionality of Brettanomyces bruxellensis strains in wort fermentations. Journal of the Institute of Brewing, 125(3), pp.315–325.
Van Zandycke, S., 2012. Yeast. In: The Oxford Companion to Beer, 1st ed. New York: Oxford University Press, pp.858-861.
Wade, M., Strickland, M., Osborne, J. and Edwards, C., 2018. Role of Pediococcus in Winemaking. Australian Journal of Grape and Wine Research, 25(1), pp.7-24.
White, C. and Zainasheff, J., 2010. Yeast. Boulder, Colorado: Brewers Publications.
White, C., 2012. Lactobacillus. In: The Oxford Companion to Beer, 1st ed. New York: Oxford University Press, pp.531.
Yakobson, C., 2012. Brettanomyces. In: The Oxford Companion to Beer, 1st ed. New York: Oxford University Press, pp.157-158.
{"one"=>"Select 2 or 3 items to compare", "other"=>"{{ count }} of 3 items selected"}